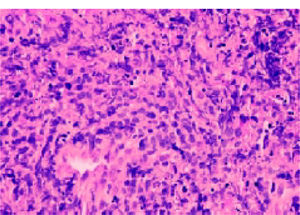
18-gauge French liver core biopsy at x400 magnification showing a diffuse infiltrate of predominantly large neoplastic lymphoid cells, with strong membrane staining for CD20 indicative of diffuse large B cell lymphoma and, in this context, consistent with monomorphic Post Transplant Lym-phoproliferative Disorder (PTLD).

Post-transplant lymphoproliferative disorder (PTLD) is a serious and potentially fatal complication of solid organ transplantation. It is the commonest malignancy in this population (excluding non melanoma skin cancer and in situ cervical cancer), accounting for 10 percent of all malignancies.1 The overall risk of PTLD in SOT recipients is between 1 and 2%.2 Extra nodal involvement is common, occurring in approximately 30 to 70 percent of cases of PTLD3. Hepatic involvement typically occurs as part of extra nodal involvement and may also rarely present as localized hepatic lymphoma.
The highest incidence of lymphoma occurs during the first year, cumulative risk increases in subsequent years and at 10 years the relative risk is 11.8-fold, compared with that of the nontransplant population.4 The aetiology appears to be related to B cell proliferation induced by infection with Epstein-Barr virus (EBV) in the setting of chronic immunosuppression resulting in a deficiency of EBV-specific cytotoxic T lymphocytes (CTL). Predisposing factors include EBV mismatch between donor and recipient, use of immunosuppression especially T-cell depletive therapies and genetic predisposition of recipients. Hepatitis B virus (HBV) reactivation has been suggested as a risk factor for non-Hodgkin’s lymphoma.5
Therapy includes immune modulation via reduction in immunosuppresion, anti B-cell monoclonal antibody (rituximab), and cellular therapy. Despite all these highly effective treatment for PTLD, mortality rates remain high.
A 45 year old man with a history of IgA nephropathy underwent renal transplant eight years previously. His background history was significant with chronic hepatitis B, on lamivudine and strong family history of hepatocellular carcinoma. His hepatitis B viral DNA was undetectable on treatment. His post transplant course was unremarkable on maintenance regimen of tacrolimus, azathioprine and low dose prednisone until presented with several weeks of high fever 39.5C, low back pain and grossly abnormal liver function test (GGT 862IU/L, ALP 308IU/L, Bilirubin 49 mmol/L (total), 36 mmol/L (direct), AST 137 IU/L, ALT 120 IU/L, LDH 843 IU/L, Alb 25 gm/dL). CT scan of the abdomen revealed multiple hypoattenuating masses extending to the liver surfaces, measuring from 0.2 to 2.0 cm. He also had mild ascites and periportal lymphadenopathy. Initial differentials include hepatitis B associated hepatocellular carcinoma; however there was no evidence of HBV reactivation. MRI suggested impending cord compression as abnormal soft tissue in the anterior epidural space at C5-6 and L5-S1. A transjugular liver biopsy was performed and diagnosed with aggressively behaving, post transplant lymphoproliferative disease (Diffuse large B-cell lymphomaimage) (Figures 1 and 2). He developed auto tumour lysis syndrome and deteriorated rapidly. Treatment attempted with cyclophosphamide, dexamethasone and rituximab. Patient died in ICU on day 10 of treatment from multiorgan failure secondary to septic shock and tumour lysis syndrome.
18-gauge French liver core biopsy at x400 magnification showing a diffuse infiltrate of predominantly large neoplastic lymphoid cells, with strong membrane staining for CD20 indicative of diffuse large B cell lymphoma and, in this context, consistent with monomorphic Post Transplant Lym-phoproliferative Disorder (PTLD).